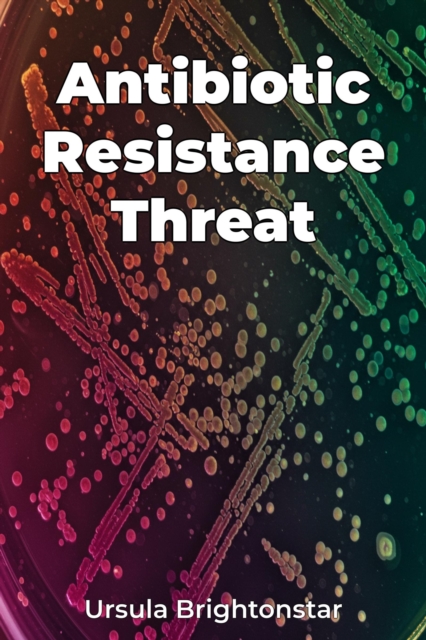
Antibiotic Resistance Threat

Antibiotic Resistance Threat
Antibiotic resistance is a growing global health crisis threatening our ability to treat common infections. Antibiotic Resistance Threat explores the origins, mechanisms, and impact of resistant bacteria, highlighting the urgent need for action. A key insight is how bacteria develop resistance through genetic mutations, enabling them to evade the effects of antibiotics. Factors such as antibiotic ...
Antibiotic resistance is a growing global health crisis threatening our ability to treat common infections. Antibiotic Resistance Threat explores the origins, mechanisms, and impact of resistant bacteria, highlighting the urgent need for action. A key insight is how bacteria develop resistance through genetic mutations, enabling them to evade the effects of antibiotics. Factors such as antibiotic ...
